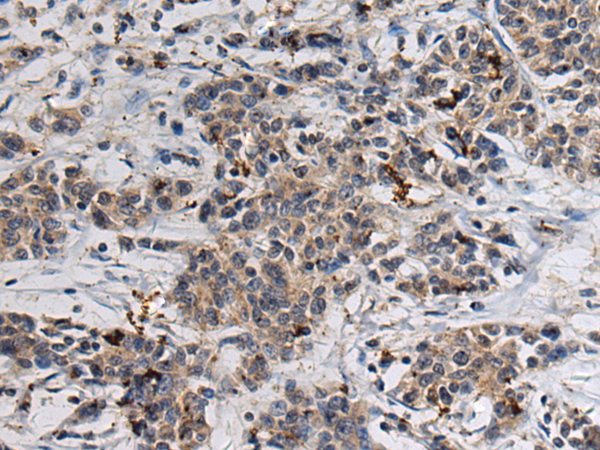

中文名稱: 兔抗GABARAP多克隆抗體
技術(shù)規(guī)格
|
Background: |
Gamma-aminobutyric acid A receptors [GABA(A) receptors] are ligand-gated chloride channels that mediate inhibitory neurotransmission. This gene encodes GABA(A) receptor-associated protein, which is highly positively charged in its N-terminus and shares sequence similarity with light chain-3 of microtubule-associated proteins 1A and 1B. This protein clusters neurotransmitter receptors by mediating interaction with the cytoskeleton. [provided by RefSeq, Jul 2008] |
|
Applications: |
ELISA, WB, IHC |
|
Name of antibody: |
GABARAP |
|
Immunogen: |
Fusion protein of human GABARAP |
|
Full name: |
GABA type A receptor-associated protein |
|
Synonyms: |
MM46; ATG8A; GABARAP-a |
|
SwissProt: |
O95166 |
|
ELISA Recommended dilution: |
5000-10000 |
|
IHC positive control: |
Human colorectal cancer |
|
IHC Recommend dilution: |
150-300 |
|
WB Predicted band size: |
14 kDa |
|
WB Positive control: |
HepG2 cell lysate |
|
WB Recommended dilution: |
500-2000 |

購物車
購物車 幫助
幫助
 021-54845833/15800441009
021-54845833/15800441009
